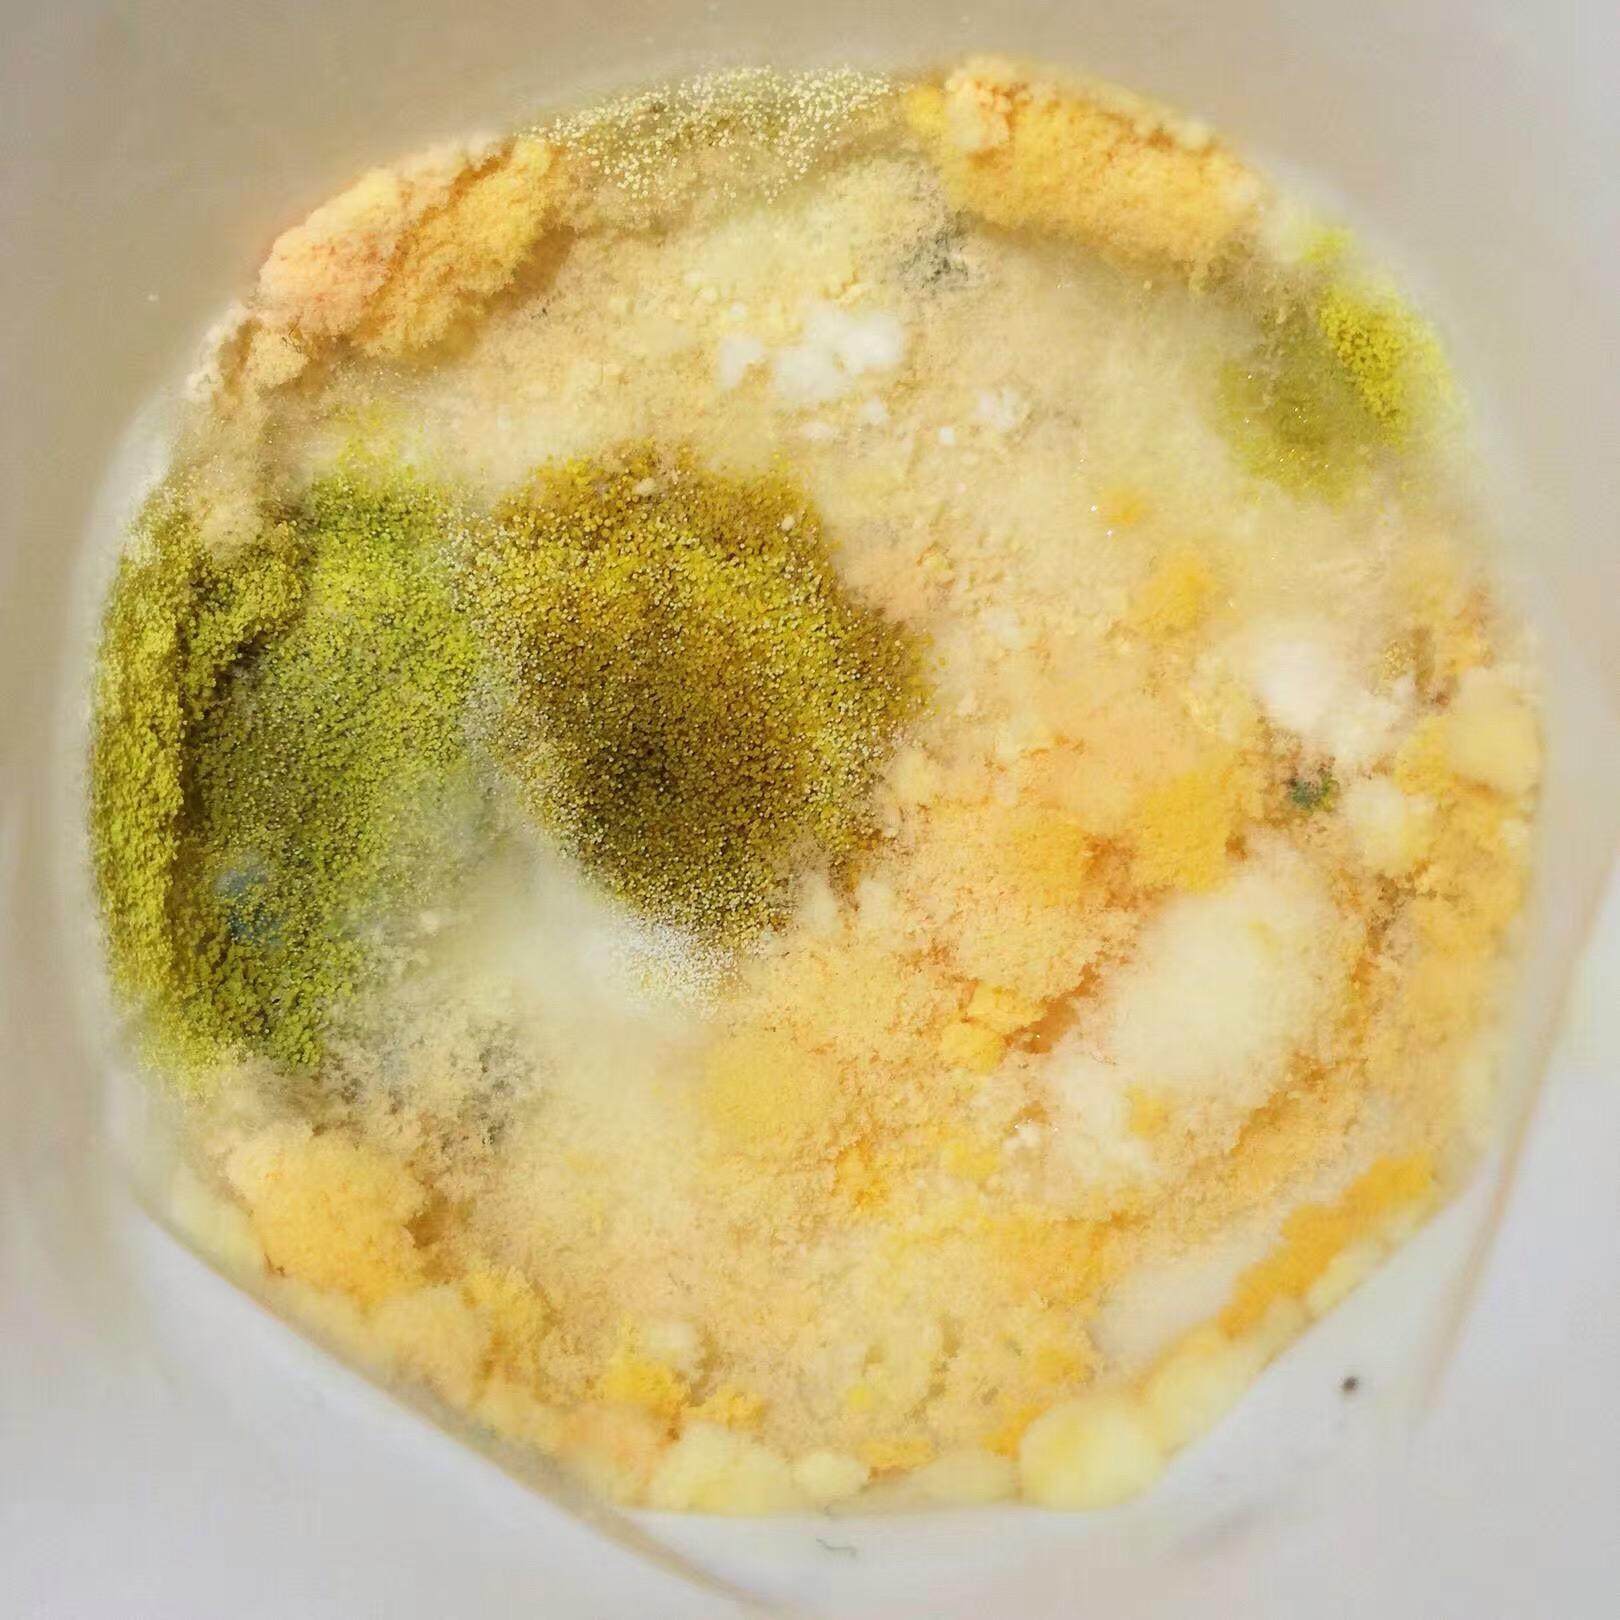
知乎

绿霉菌

绿色真菌霉菌通过显微镜在变质食品宏观视野上的传播
图片尺寸700x467
绿色霉菌在变质食品上的传播, 通过显微镜观察
图片尺寸700x467
你好老师香菇传菌过程中出现绿霉菌怎么处理
图片尺寸864x1152
近距离观察一片面包上的绿霉,食物上的霉菌
图片尺寸1200x800
老师您好香菇菌棒出菇期有绿霉菌怎么办
图片尺寸2309x1732
苹果酱上有霉菌
图片尺寸1200x801
食用菌绿霉处理
图片尺寸1024x768
一款战争中催生的新药以及一名拯救了数百万生命的科学家
图片尺寸800x590
食物上绿霉菌的生长,真菌的传播,近景抽象背景
图片尺寸1200x800
绿色发霉的面包
图片尺寸1200x704
食物上绿霉菌的生长,真菌的传播,近景抽象背景
图片尺寸1200x800
排序|按时间排序 2条回答 2009-08-05 13:12鼠有牙|五级 明显是霉菌
图片尺寸1280x960
costco最近品控有问题刚买的面饼发霉变绿恶心吐了
图片尺寸924x1847
全麦面包详细一片全麦面包长满了食物霉菌在绿板上的特写照片
图片尺寸368x300
问题描述:贵州基地香菇菌棒 出现这种病变,是绿霉吗?需要怎么处理?
图片尺寸800x1600
绿色黄色圆形霉菌在异质黑色表面, 宏观抽象背景
图片尺寸700x700
灵芝都绿了
图片尺寸640x853
知乎
图片尺寸1620x1620
蛋糕生产企业解决霉菌污染问题方案
图片尺寸800x519
绿霉菌危害特点以及防治方法
图片尺寸600x439